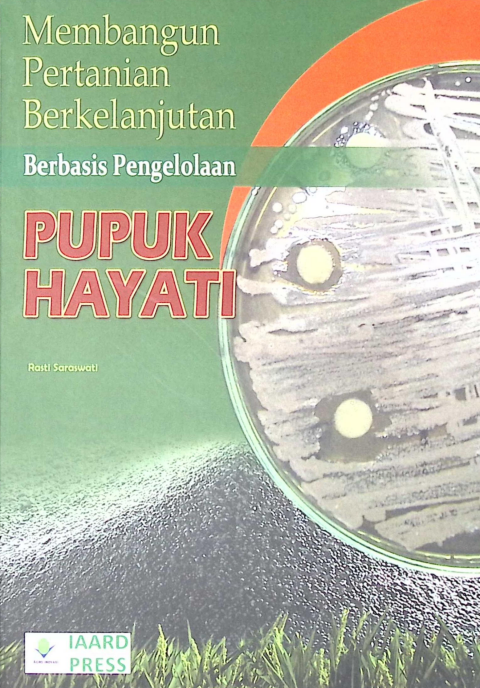
Cover PUPUK HAYATI (2)

Klik untuk detail
RENCANA DAERAH PERMUKIMAN GOAL
Tahun: 1984
rencana daerah permukiman goal

Klik untuk detail
REKOMENDASI PEMUPUKAN N,P, DAN K PADA PADI SAWAH SPESIFIK LOKASI
Tahun: 2007
REKOMENDASI PEMUPUKAN N,P, DAN K PADA PADI SAWAH SPESIFIK LOKASI

Klik untuk detail
REKOMENDASI PEMUPUKAN N, P, DAN K PADA PADI SAWAH SPESIFIK LOKASI
Tahun: 2015
REKOMENDASI PEMUPUKAN N, P, DAN K PADA PADI SAWAH SPESIFIK LOKASI

Klik untuk detail
REKOMENDASI PAKET TEKNOLOGI PERTANIAN
Tahun: 2005
REKOMENDASI Paket Teknologi Pertanian

Klik untuk detail
RECONNAISSANCE
Tahun: 1983
RECONNAISSANCE

Klik untuk detail
RAPAT KERJA II BADAN LITBANG PERTANIAN
Tahun: 1998
rapat kerja II badan litbang pertanian

Klik untuk detail
RAPAT KERJA II BADAN LITBANG PERTANIAN TAHUN2012
Tahun: 2012
RAPAT KERJA II BADAN LITBANG PERTANIAN TAHUN2012

Klik untuk detail
RANGKUMAN HASIL PENLITIAN ARAHAN PERCEPATAN PEMBANGUNAN PERTANIAN BERBASIS SUMBERDAYA
Tahun: 2007
RANGKUMAN HASIL PENLITIAN ARAHAN PERCEPATAN PEMBANGUNAN PERTANIAN BERBASIS SUMBERDAYA

Klik untuk detail
RAGAM KEBIJAKAN SUMBERDAYA LAHAN
Tahun: 2019
RAGAM KEBIJAKAN SUMBERDAYA LAHAN

Klik untuk detail
PUSAT PENELITIAN TANAH DAN AGROKLIMAT
Tahun: 1998
PUSAT PENELITIAN TANAH DAN AGROKLIMAT

Klik untuk detail
PUPUK HAYATI
Tahun: 2009
PUPUK HAYATI
Klik untuk detail
PUPUK HAYATI (2)
Tahun: 2009
PUPUK HAYATI (2)